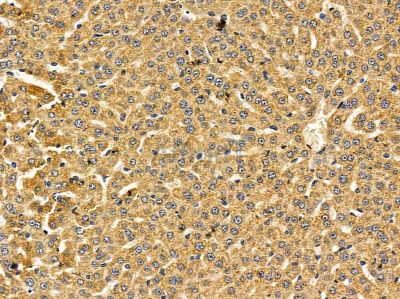
TGM3 Antibody - DF14512 at 1/100 staining rat liver tissue by IHC-P.

TGM3 Antibody - #DF14512
Related Downloads
Protocols
Product Info
*The optimal dilutions should be determined by the end user. For optimal experimental results, antibody reuse is not recommended.
*Tips:
WB: For western blot detection of denatured protein samples. IHC: For immunohistochemical detection of paraffin sections (IHC-p) or frozen sections (IHC-f) of tissue samples. IF/ICC: For immunofluorescence detection of cell samples. ELISA(peptide): For ELISA detection of antigenic peptide.
Fold/Unfold
E polypeptide protein glutamine gamma glutamyltransferase; MGC126249; MGC126250; Protein glutamine gamma glutamyltransferase E 27 kDa catalytic chain; Protein glutamine gamma glutamyltransferase E 50 kDa noncatalytic chain; Protein glutamine gamma glutamyltransferase E; Protein-glutamine gamma-glutamyltransferase E 27 kDa non-catalytic chain; TG(E); TGase E; TGase-3; TGE; TGM 3; TGM3; TGM3_HUMAN; Transglutaminase E; Transglutaminase-3; Transglutaminase3; TransglutaminaseE;
Immunogens
A synthesized peptide derived from human TGM3.
- Q08188 TGM3_HUMAN:
- Protein BLAST With
- NCBI/
- ExPASy/
- Uniprot
MAALGVQSINWQTAFNRQAHHTDKFSSQELILRRGQNFQVLMIMNKGLGSNERLEFIVSTGPYPSESAMTKAVFPLSNGSSGGWSAVLQASNGNTLTISISSPASAPIGRYTMALQIFSQGGISSVKLGTFILLFNPWLNVDSVFMGNHAEREEYVQEDAGIIFVGSTNRIGMIGWNFGQFEEDILSICLSILDRSLNFRRDAATDVASRNDPKYVGRVLSAMINSNDDNGVLAGNWSGTYTGGRDPRSWNGSVEILKNWKKSGFSPVRYGQCWVFAGTLNTALRSLGIPSRVITNFNSAHDTDRNLSVDVYYDPMGNPLDKGSDSVWNFHVWNEGWFVRSDLGPSYGGWQVLDATPQERSQGVFQCGPASVIGVREGDVQLNFDMPFIFAEVNADRITWLYDNTTGKQWKNSVNSHTIGRYISTKAVGSNARMDVTDKYKYPEGSDQERQVFQKALGKLKPNTPFAATSSMGLETEEQEPSIIGKLKVAGMLAVGKEVNLVLLLKNLSRDTKTVTVNMTAWTIIYNGTLVHEVWKDSATMSLDPEEEAEHPIKISYAQYEKYLKSDNMIRITAVCKVPDESEVVVERDIILDNPTLTLEVLNEARVRKPVNVQMLFSNPLDEPVRDCVLMVEGSGLLLGNLKIDVPTLGPKEGSRVRFDILPSRSGTKQLLADFSCNKFPAIKAMLSIDVAE
Research Backgrounds
Catalyzes the calcium-dependent formation of isopeptide cross-links between glutamine and lysine residues in various proteins, as well as the conjugation of polyamines to proteins. Involved in the formation of the cornified envelope (CE), a specialized component consisting of covalent cross-links of proteins beneath the plasma membrane of terminally differentiated keratinocytes. Catalyzes small proline-rich proteins (SPRR1 and SPRR2) and LOR cross-linking to form small interchain oligomers, which are further cross-linked by TGM1 onto the growing CE scaffold (By similarity). In hair follicles, involved in cross-linking structural proteins to hardening the inner root sheath.
Activated by proteolytic processing. In vitro activation is commonly achieved by cleavage with dispase, a neutral bacterial protease. Dispase cleavage site was proposed to lie between Ser-470 and Ser-471 or between Pro-465 and Phe-466. Physiological activation may be catalyzed by CTSL and, to a lesser extent, by CTSS, but not by CTSB, CTSD nor CTSV.
Cytoplasm.
Belongs to the transglutaminase superfamily. Transglutaminase family.
Restrictive clause
Affinity Biosciences tests all products strictly. Citations are provided as a resource for additional applications that have not been validated by Affinity Biosciences. Please choose the appropriate format for each application and consult Materials and Methods sections for additional details about the use of any product in these publications.
For Research Use Only.
Not for use in diagnostic or therapeutic procedures. Not for resale. Not for distribution without written consent. Affinity Biosciences will not be held responsible for patent infringement or other violations that may occur with the use of our products. Affinity Biosciences, Affinity Biosciences Logo and all other trademarks are the property of Affinity Biosciences LTD.